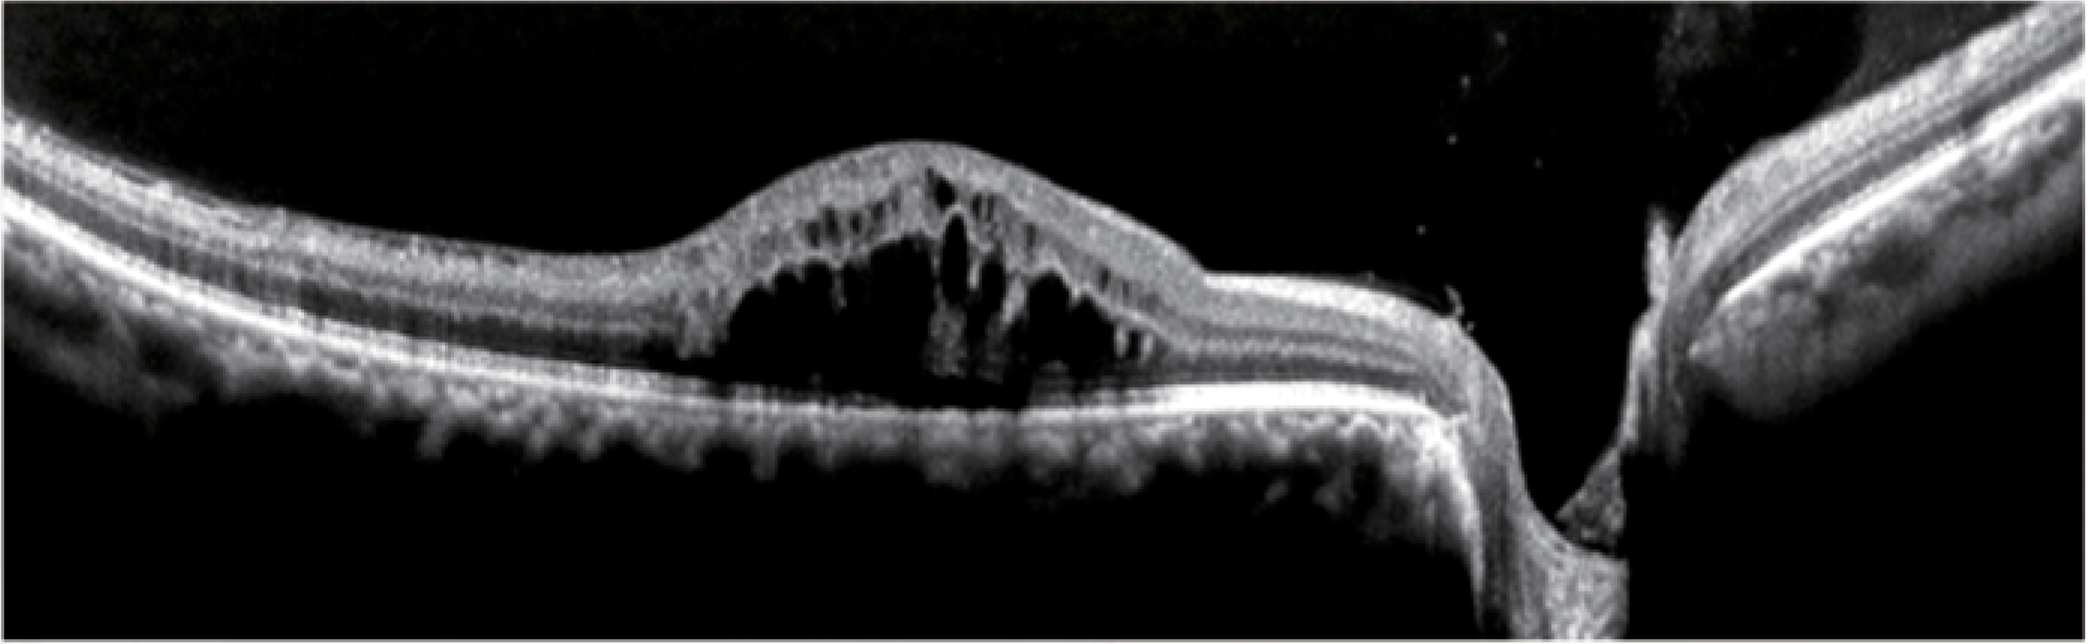
OCT Velite C-3000 OCT-ANGIO Alta Velocidad / Ultra Alta Resolución

OCT Velite C-3000 OCTA 120K/200K
*PRECIO PUBLICADO SIN IVA / *PARA DESCUENTOS POR PROYECTO CONTACTARSE A ATENCION AL CLIENTE.
Ultra HD - Resolución de imagen de adquisición de hasta 8K
Valores incluyen PC, Instalación y Capacitación.
Garantía 24 meses y Servicio técnico exclusivo.
Ultra Alta velocidad: 120.000 a 200.000 escaneos A por segundo
Inteligencia: el análisis asistido por IA facilita el diagnóstico
Imágenes de ultra alta resolución y gran angular: visualización nítida de los vasos del fondo de ojo.
Imágenes de alta definición de la microcirculación vascular ·
Integración de funciones: Seguimiento vascular general - Seguimiento vascular inteligente - Identificación de la microcirculación - Análisis de la zona avascular foveal
Visualización de imágenes 3D del fondo de ojo: Gran detalle entre capas
Imágenes de alta resolución del fondo de ojo
Detección del segmento anterior · Medición precisa
Detección de glaucoma y mácula · Análisis automático
Reconocimiento de IA para enfermedades oculares · Localización precisa de enfermedades oculares
Características
- Prevención y control de la miopía
- Detección de retinopatía diabética
- Detección de enfermedades oculares en personas mayores
- Medición automática de la estratificación de la membrana coroidea (Prueba de precisión para la intervención del desarrollo de la miopía)
- Medición automática del grosor; no requiere estratificación manual
- Monitorización del grosor antes y después de la prevención y el control de la miopía
- Autoenfoque: menor tiempo de inspección y operación más sencilla
- Estratificación con IA: cálculo automático del grosor coroideo
- Presentación automática del grosor coroideo y mapa de distribución
- Patrón de detección de glaucoma
- Análisis de glaucoma: capa de fibras nerviosas de la retina (RNFL) del disco óptico
- Adquisición única de imágenes de 12 mm x 6 mm: amplio rango de volumen del fondo de ojo
- Análisis cuantitativo y de grosor del área macular y del disco óptico
- Combinación de cinco (5) imágenes de 16 x 16 mm (Módulo Mosaico)

Reporte generado por I.A. incluido

Casos clínicos con Velite C-3000:

Retinopatia diabetica (RD)

Membrana epirretiniana (MER)

Retinosquisis

Neovascularización coroidea

Obstrucción de la rama venosa retiniana

Agujero Macular (MH)
 Coriorretinopatía serosa central
Coriorretinopatía serosa central
GENERALFOCUS ES REPRESENTANTE EXCLUSIVO EN CHILE DE WRMT
Pairs well with
Despacho a todo Chile
Pago seguro
Distribución autorizada

OCT Velite C-3000 OCTA 120K/200K
Si tiene alguna pregunta, no dude en contactarnos. Le responderemos lo antes posible, en un plazo de 24 horas entre semana.
-
Shipping Information
Use this text to answer questions in as much detail as possible for your customers.
-
Information
Share contact information, store details, and brand content with your customers.
-
Customer Support
Use this text to answer questions in as much detail as possible for your customers.
-
FAQ’s
Use this text to answer questions in as much detail as possible for your customers.
-
Contact Us
Use this text to answer questions in as much detail as possible for your customers.

